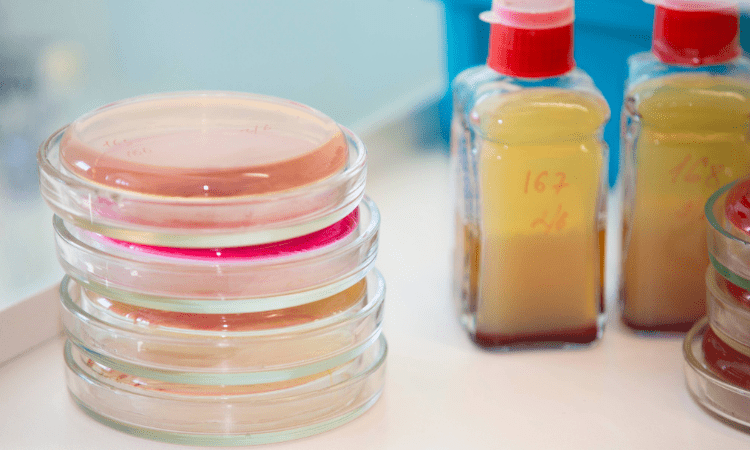
Анализ химического сырья | Качество и безопасность

Анализ химического сырья | Качество и безопасность
Важность анализа химического сырья

Анализ химического сырья: шаг к качеству и безопасности
Анализ химического сырья — это важнейший процесс, используемый для проверки качества, чистоты и свойств основных компонентов, применяемых в производстве.
Эти анализы имеют огромное значение в различных отраслях, таких как пищевая, фармацевтическая, косметическая, лакокрасочная, пластмассовая и текстильная, для обеспечения безопасности продукции, эффективности производственных процессов и соответствия стандартам качества. В этой статье мы подробно рассмотрим основы анализа химического сырья, методы анализа и их роль в промышленности.
Что такое химическое сырье?
Химическое сырье состоит из соединений или элементов, которые подвергаются химическим процессам для получения конкретного продукта или промежуточного продукта. Примерами химического сырья являются активные ингредиенты и наполнители, используемые в фармацевтическом производстве, добавки, используемые в пищевой промышленности, а также растительные и синтетические ингредиенты, используемые в косметической промышленности. Очень важно, чтобы каждое сырье было в надлежащем и надежном состоянии, чтобы обеспечить эффективность и надежность конечного продукта.
Важность анализа химического сырья
Качественный анализ химического сырья важен для предотвращения возможных отклонений в производстве и гарантии определенного стандарта качества. Низкое качество сырья может напрямую повлиять на характеристики, безопасность и удовлетворенность потребителей конечным продуктом. Кроме того, точный анализ химических компонентов делает производственные процессы более безопасными, снижая риск загрязнения.
Области применения анализа химического сырья по секторам
Анализы химического сырья могут варьироваться в зависимости от области применения. Ниже приведены некоторые из наиболее важных анализов в различных секторах:
- Пищевой сектор: Анализы, такие как определение чистоты пищевых добавок, выявление аллергенов и соотношение консервантов, имеют решающее значение для безопасности пищевых продуктов. Качество сырья и его соответствие пищевым нормам обеспечиваются посредством анализов.
- Фармацевтическая промышленность: Анализ сырья обеспечивает чистоту, стабильность, эффективность и биодоступность активных ингредиентов и вспомогательных веществ в лекарственных средствах. Анализ примесей и определение рисков загрязнения также важны в этом секторе.
- Косметическая промышленность: Сырье, используемое в косметических средствах, должно проходить анализ на чистоту, микробиологическую нагрузку и аллергенные эффекты. Химические анализы повышают безопасность этих продуктов.
- Сектор промышленной химии: Анализ долговечности, стабильности цвета и твердости химического сырья, используемого в таких отраслях, как производство пластмасс, красок и текстиля, важен для качества конечного продукта.
Преимущества анализа химического сырья
Анализ химического сырья является основой высококачественного, надежного и соответствующего законодательству производства. Определение физико-химических свойств сырья сводит к минимуму потенциальные проблемы в процессе производства и гарантирует, что конечный продукт соответствует стандартам качества. Поэтому все производители в секторе должны уделять приоритетное внимание анализу химического сырья, чтобы обеспечить эффективный и надежный производственный процесс.
- Безопасность продукции: Химический анализ обеспечивает безопасное производство за счет выявления опасных компонентов в сырье.
- Обеспечение качества: Анализ подтверждает, что качество сырья соответствует производственным стандартам. Это способствует тому, что конечный продукт отвечает ожиданиям клиентов.
- Повышение эффективности: Химический анализ сырья позволяет заранее выявить потенциальные проблемы в производственном процессе и сократить потери. Это обеспечивает более плавный и эффективный ход производственного процесса.
- Соблюдение нормативных требований: Анализ сырья обеспечивает соблюдение законодательных норм и отраслевых стандартов. Это способствует продаже продукции как на местных, так и на международных рынках.
Методы, используемые при химическом анализе сырья
Химический анализ сырья может варьироваться в зависимости от типа тестируемых компонентов и потребностей отрасли. Ниже приведены некоторые из основных используемых методов:
- Спектроскопический анализ: Спектроскопический анализ широко используется для определения компонентов и чистоты сырья. Для анализа химической структуры сырья используются такие методы, как УФ-Вис-спектрофотометрия, ФТИР-спектроскопия (инфракрасная спектроскопия с Фурье-преобразованием) и ЯМР (ядерный магнитный резонанс).
- Хроматографический анализ: Для разделения компонентов химического сырья и определения их количества используются такие методы, как газовая хроматография (ГХ), жидкостная хроматография (ВЭХ) и тонкослойная хроматография (ТСХ). Эти методы играют важнейшую роль в обнаружении примесей и анализе смесей.
- Титриметрический анализ: Титриметрические методы используются для анализа кислотно-основного баланса, окислительно-восстановительного потенциала и других свойств реактивности химических веществ. Они особенно часто применяются для определения точности концентраций сырья.
- Термический анализ: Эти анализы изучают поведение сырья в ответ на изменения температуры. Такие методы, как дифференциальная сканирующая калориметрия (ДСК) и термогравиметрический анализ (ТГА), эффективны для определения таких свойств, как температура плавления, температура кипения и стабильность веществ.
- Микроскопический анализ: Микроскопический анализ проводится для изучения размеров и форм частиц химических веществ, особенно в порошкообразной или твердой форме. Эти анализы помогают обеспечить однородность продукции путем определения морфологии частиц.
- Тесты pH и проводимости: Измерения pH и проводимости проводятся для оценки ионной чистоты и химического баланса растворов. Эти тесты необходимы для определения совместимости сырья с производственными процессами.
- Тесты на примеси и тяжелые металлы: Особенно в пищевой, косметической и фармацевтической промышленности примеси и тяжелые металлы в сырье представляют значительный риск для здоровья. Анализ примесей проводится с использованием таких методов, как индуктивно-связанная плазма (ICP) и масс-спектрометрия (MS).
ПОЧЕМУ NANOLAB?
Nanolab предлагает самые надежные и быстрые решения в области анализа химического сырья благодаря своему опыту в отрасли и надежной инфраструктуре. Мы анализируем химический состав сырья с максимальной точностью, чтобы обеспечить соответствие ваших продуктов требованиям к качеству и безопасности. Благодаря аккредитации по стандарту ISO 17025 результаты испытаний имеют международную силу, а пригодность сырья тщательно оценивается. Благодаря обширному парку оборудования и команде технических экспертов компания эффективно выполняет аналитические процессы и предоставляет быстрые результаты. Благодаря экспертизе в области нормативно-правового регулирования при анализе сырья в полной мере соблюдаются все законодательные требования. Nanolab выделяется как компания, в которой качество, надежность и скорость объединяются в области анализа химического сырья.
Для получения дополнительной информации, пожалуйста, свяжитесь с нами.
Вы можете следить за нами на LinkedIn, чтобы быть в курсе последних новостей и обновлений о наших услугах.
Подпишитесь на наш аккаунт в Instagram, чтобы быть в курсе последних публикаций в нашем блоге.